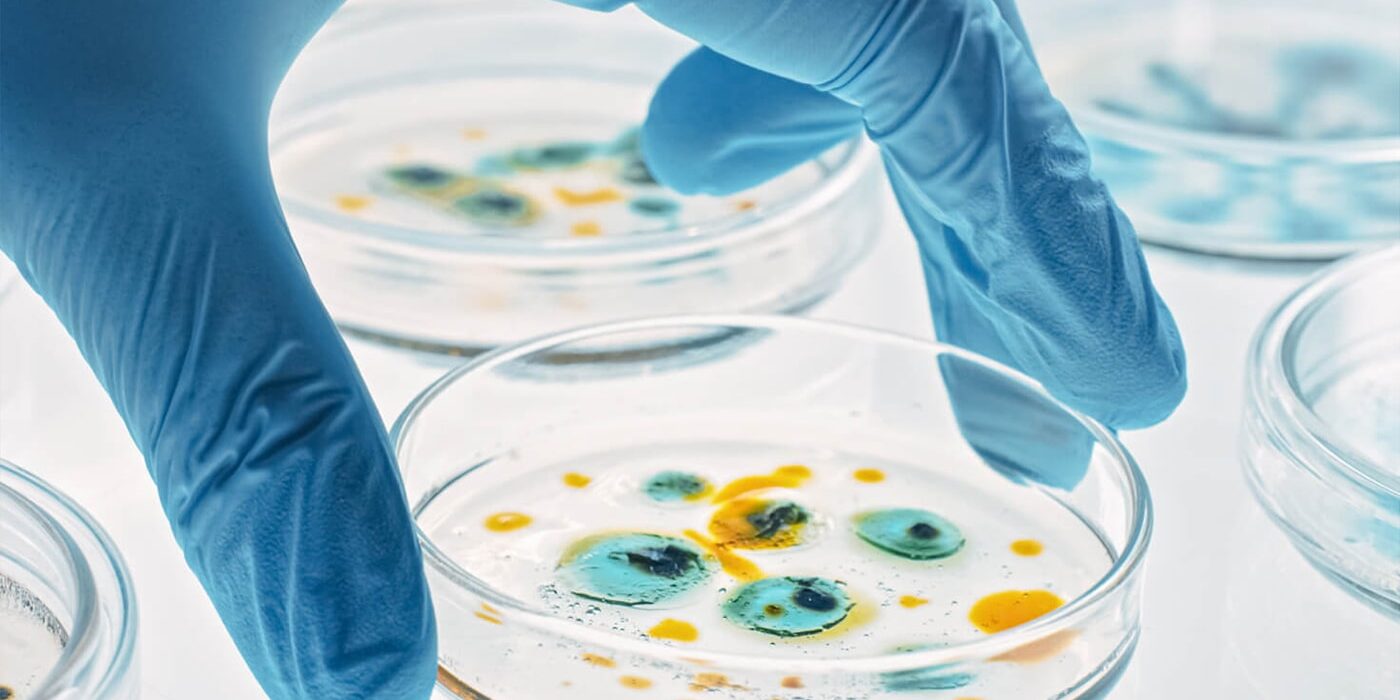
project-img

Morbi porta dolor quis sem ultricies maximus. Nunc accumsan dui vel lobortis pulvinar. Duis convallis odio ut dignissim faucibus. Sed sit amet urna dictum, interdum justo sed, lacinia dolor. Phasellus finibus nunc id tellus mollis consequat. Maecenas ornare aliquet vestibulum. Integer leo magna, viverra a imperdiet id, vehicula non mi. Vestibulum nec arcu dolor.
Nunc accumsan dui vel lobortis pulvinar. Duis convallis odio ut dignissim faucibus. Sed sit amet urna dictum, interdum justo sed, lacinia dolor. Phasellus finibus nunc id tellus mollis consequat. Maecenas ornare aliquet vestibulum. Integer leo magna, viverra a imperdiet id, vehicula non mi. Vestibulum nec arcu dolor. Nunc accumsan dui vel lobortis pulvinar. Duis convallis odio ut dignissim faucibus. Sed sit amet urna dictum, interdum justo sed, lacinia dolor.
Project Overview
Vestibulum morbi blandit cursus risus. Augue neque
gravida in fermentum et sollicitudin.
- Nunc accumsan dui vel lobortis pulvinar.
- Duis convallis odio ut dignissim faucibus.
- Sed sit amet urna dictum, interdum justo sed.
- Maecenas ornare aliquet vestibulum.
Medical Health Research
Duis convallis odio ut dignissim faucibus. Sed sit amet urna dictum, interdum justo sed, lacinia dolor. Phasellus finibus nunc id tellus mollis consequat. Maecenas ornare aliquet vestibulum.
Vestibulum morbi blandit cursus risus. Egestas maecenas pharetra convallis posuere morbi leo urna. In egestas erat imperdiet sed euismod nisi porta lorem. Porttitor leo a diam sollicitudin tempor id eu nisl.
Vestibulum morbi blandit cursus risus. Egestas maecenas pharetra convallis posuere morbi leo urna. In egestas erat imperdiet sed euismod nisi porta lorem. Porttitor leo a diam sollicitudin tempor id eu nisl.
Vestibulum morbi blandit cursus risus. Egestas maecenas pharetra convallis posuere morbi leo urna. In egestas erat imperdiet sed euismod nisi porta lorem. Porttitor leo a diam sollicitudin tempor id eu nisl.